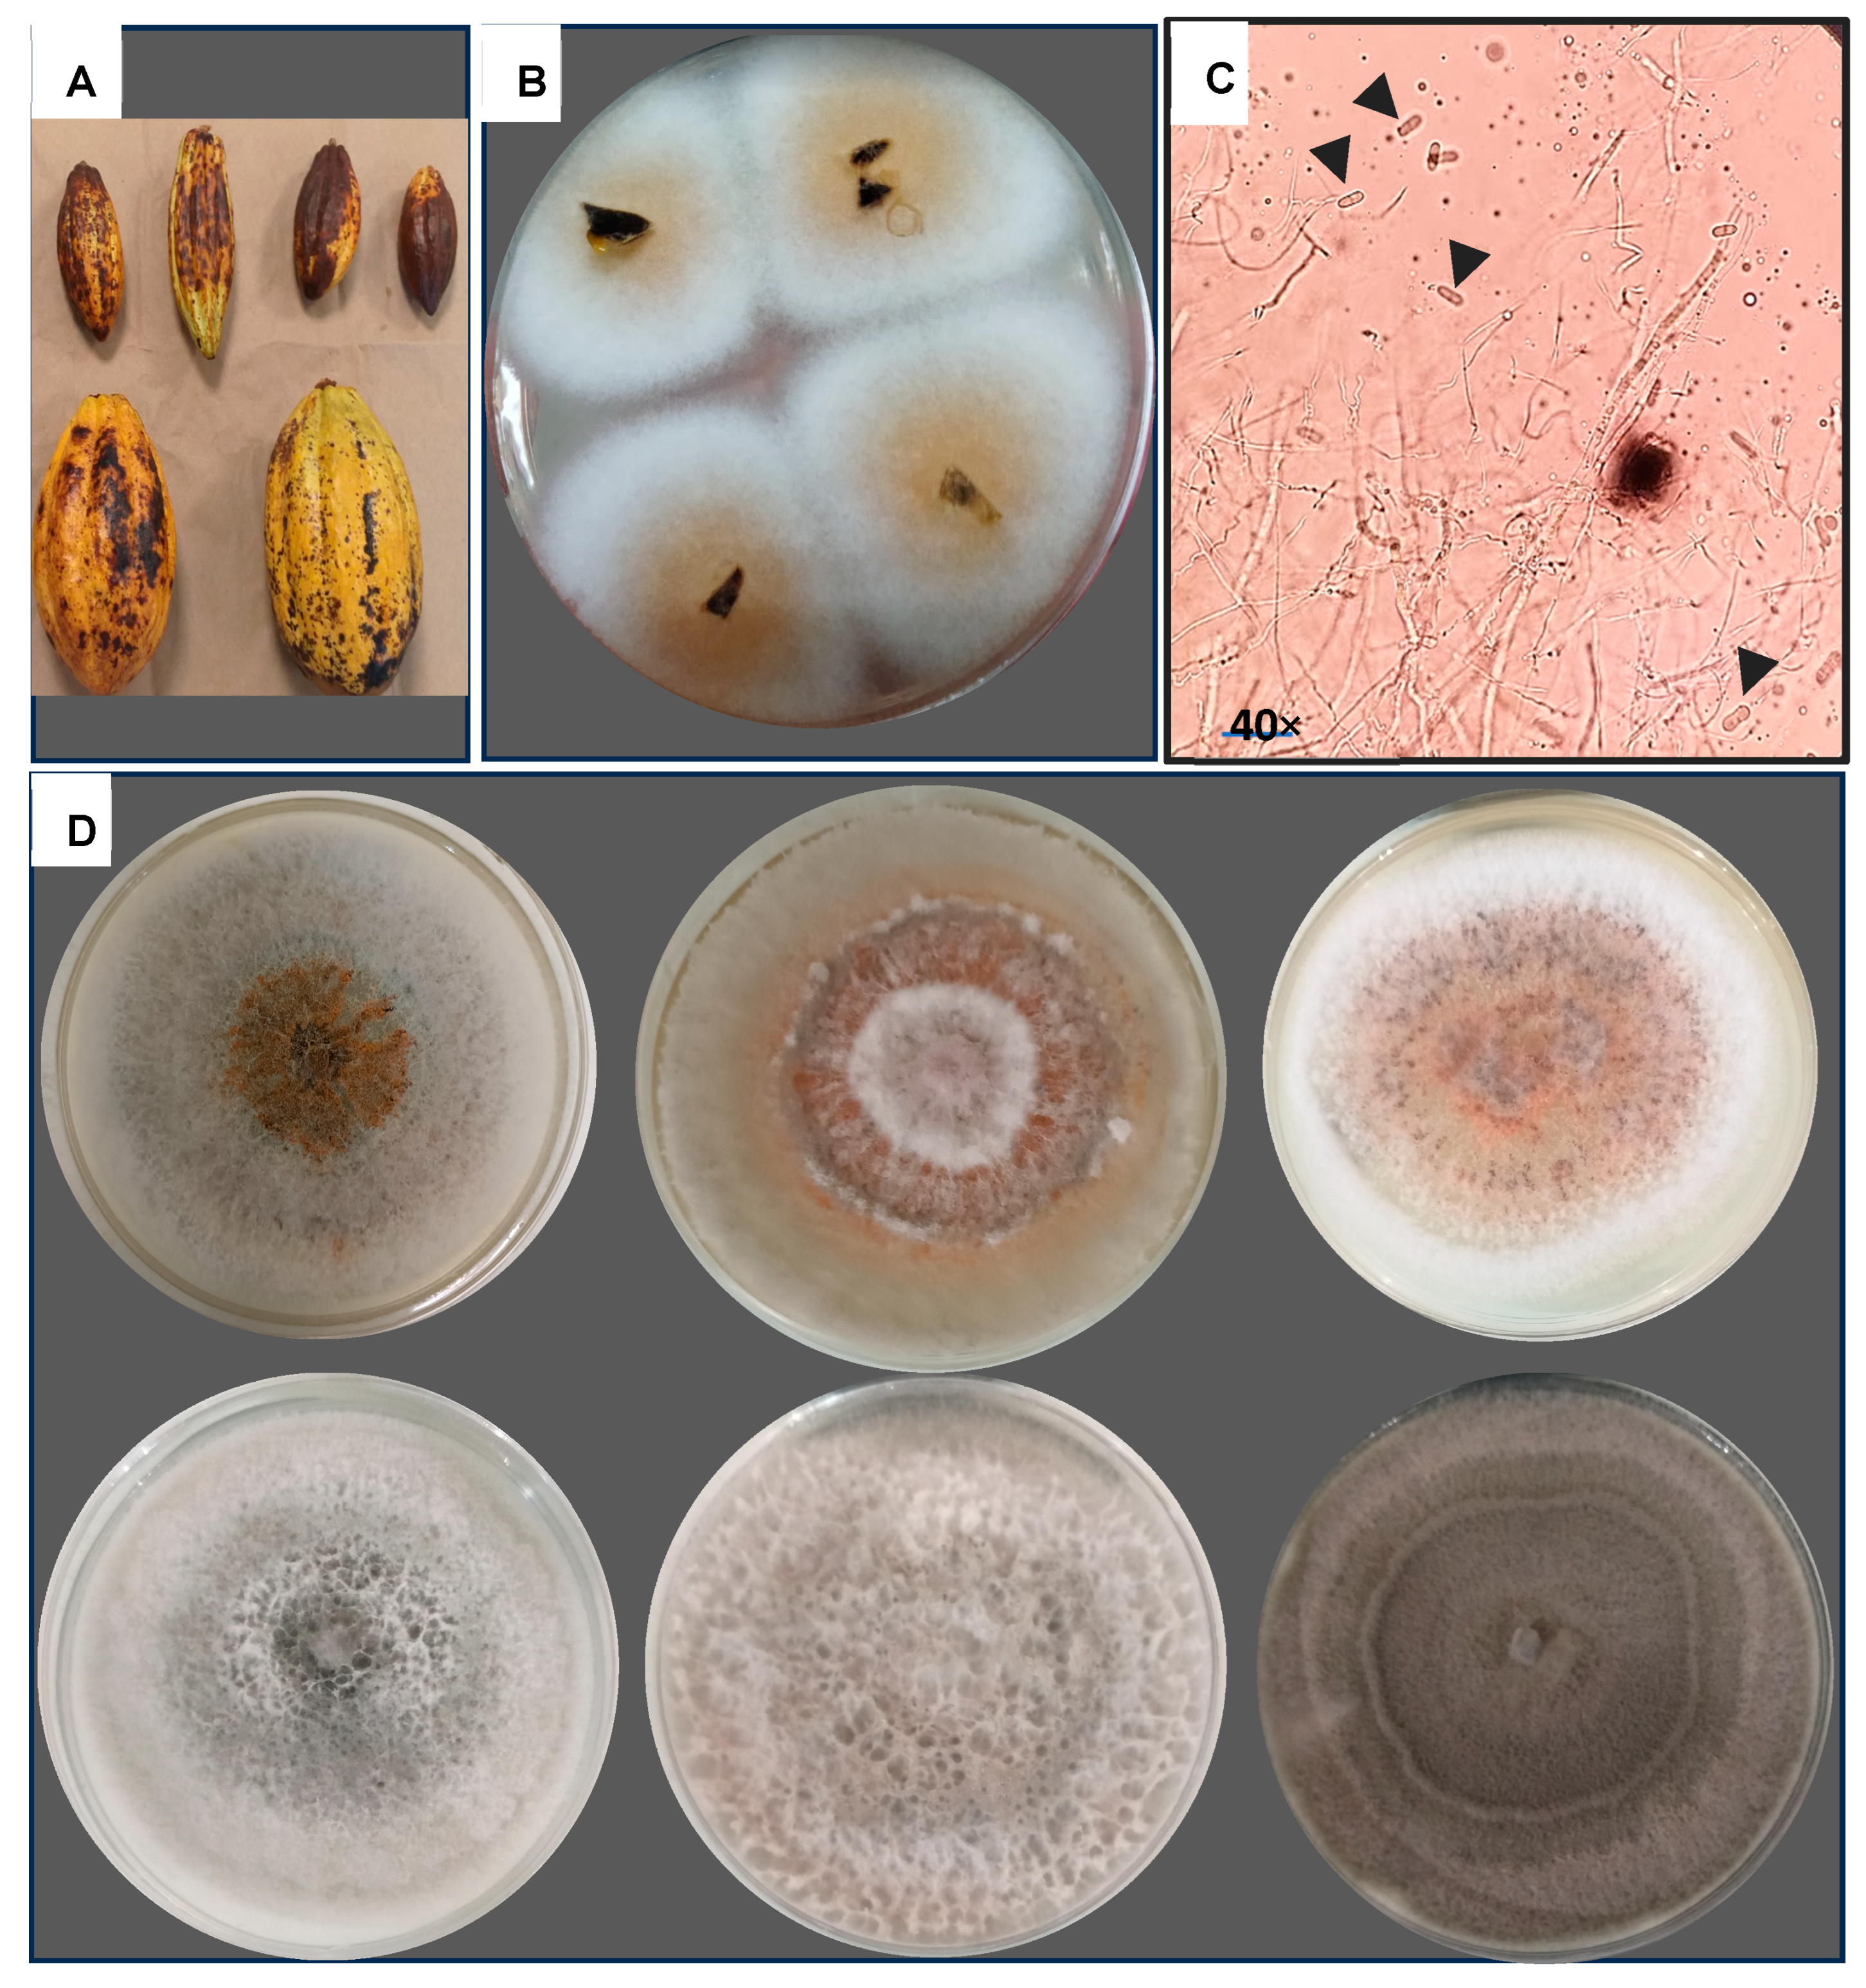
Jof 11 00312 g002

Isolation and Biological Control of Colletotrichum sp. Causing Anthracnosis in Theobroma cacao L. in Chiapas, Mexico
Abstract
1. Introduction
2. Materials and Methods
2.1. Survey Location
2.2. Incidence of Anthracnose
2.3. Isolation of Colletotrichum sp.
2.4. Molecular Identification
2.5. Morphologic and Physiologic Fungal Characterization
2.6. Colletotrichum sp. Clustering Using Morphological and Physiological Characteristics
2.7. Pathogenicity Analysis
2.8. Efficacy of Paenibacillus sp. NMA1017 on Colletrotrichum sp. In Vitro
2.9. Efficacy of Paenibacillus sp. NMA1017 on Colletrotrichum sp. in the Field
2.10. Trapping of Phytopathogen Spores
2.11. Bacterial Effect on Mycelial Growth and Morphology
2.12. Data Analysis
3. Results
3.1. Anthracnose Incidence
3.2. Colletotrichum sp. Isolation
3.3. Molecular Identification
3.4. Morphological and Physiological Characterization of Colletrotrichum sp.
3.5. Colletotrichum sp. Clustering Using Morphological and Physiological Characteristics
3.6. Pathogenicity Test
3.7. Inhibition of Colletrotrichum sp. by Paenibacillus sp. NMA1017 In Vitro
3.8. Field Bioassays with Cacao Trees
3.9. Trapping of Phytopathogen Spores and Phytopathogen and Bacterial Isolation
3.10. Bacterial Effect on Colletotrichum sp.
4. Discussion
5. Conclusions
Supplementary Materials
Author Contributions
Funding
Institutional Review Board Statement
Informed Consent Statement
Data Availability Statement
Acknowledgments
Conflicts of Interest
References
- Sharma, M.; Kulshrestha, S. Colletotrichum gloeosporioides: An anthracnose causing pathogen of fruits and vegetables. Biosci. Biotechnol. Res. Asia 2015, 12, 1233–1246. [Google Scholar] [CrossRef]
- Zakaria, L. Diversity of Colletotrichum species associated with anthracnose disease in tropical fruit crops, a review. Agriculture 2021, 11, 297. [Google Scholar] [CrossRef]
- da Silva, L.L.; Moreno, H.L.A.; Correia, H.L.N.; Santana, M.F.; de Queiroz, M.V. Colletotrichum: Species complexes, lifestyle, and peculiarities of some sources of genetic variability. Appl. Microbiol. Biotechnol. 2020, 104, 1891–1904. [Google Scholar] [CrossRef] [PubMed]
- Rodríguez-Velázquez, N.D.; Gómez-de la Cruz, I.; Chávez-Ramírez, B.; Estrada-de los Santos, P. Biological control of diseases in Theobroma cacao. In Plant and Soil Microbiome: Biocontrol Agents for Improved Agriculture; Kumar, A., White, J., Singh, J., Eds.; Academic Press: Cambridge, MA, USA, 2024; pp. 101–104. [Google Scholar] [CrossRef]
- Mendgen, K.; Hahn, M. Plant infection and the establishment of fungal biotrophy. Trends Plant Sci. 2002, 7, 352–356. [Google Scholar] [CrossRef] [PubMed]
- Perfect, S.E.; Hughes, H.B.; O’Connell, R.J.; Green, J.R. Colletotrichum: A model genus for studies on pathology and fungal-plant interactions. Fungal Genet. Biol. 1999, 27, 186–198. [Google Scholar] [CrossRef]
- Barimani, M.; Pethybridge, S.J.; Vaghefi, N.; Hay, F.S.; Taylor, P.W.J. A new anthracnose disease of pyrethrum caused by Colletotrichum tanaceti sp. nov. Plant Pathol. 2013, 62, 1248–1257. [Google Scholar] [CrossRef]
- Jeschke, P.; Starikov, E.B. Agricultural Biocatalysis: Biological and Chemical Applications, 1st ed.; Jenny Stanford Publishing: New York, NY, USA, 2022; 458p. [Google Scholar] [CrossRef]
- Rojas, E.I.; Rehner, S.A.; Samuels, G.J.; Van Bael, S.A.; Herre, E.A.; Cannon, P.; Chen, R.; Pang, J.; Wang, R.; Zhang, Y.; et al. Colletotrichum gloeosporioides s.l. associated with Theobroma cacao and other plants in Panama: Multilocus phylogenies distinguish host-associated pathogens from asymptomatic endophytes. Mycologia 2010, 102, 1318–1338. [Google Scholar] [CrossRef]
- Siddiqui, Y.; Ali, A. Colletotrichum gloeosporioides (Anthracnose). In Postharvest Decay; Bautista-Baños, S., Ed.; Academic Press: Cambridge, MA, USA, 2014; pp. 337–371. [Google Scholar] [CrossRef]
- Fuentes-Aragón, D.; Silva-Rojas, H.V.; Guarnaccia, V.; Mora-Aguilera, J.A.; Aranda-Ocampo, S.; Bautista-Martínez, N.; Téliz-Ortíz, D. Colletotrichum species causing anthracnose on avocado fruit in Mexico: Status. Plant Pathol. 2020, 69, 1513–1528. [Google Scholar] [CrossRef]
- Cristóbal-Martínez, A.L.; de Jesús Yáñez-Morales, M.; Solano-Vidal, R.; Segura-León, O.; Hernández-Anguiano, A.M. Diversity of Colletotrichum species in coffee (Coffea arabica) plantations in Mexico. Eur. J. Plant Pathol. 2017, 147, 605–614. [Google Scholar] [CrossRef]
- Rojo-Báez, I.; Álvarez-Rodríguez, B.; García-Estrada, R.S.; León-Félix, J.; Sañudo-Barajas, A.; Allende-Molar, R. Situación actual de Colletotrichum spp. en México: Taxonomía, caracterización, patogénesis y control. Rev. Mex. Fitopatol. 2017, 35, 549–570. [Google Scholar] [CrossRef]
- Cortaga, C.Q.; Cordez, B.W.P.; Dacones, L.S.; Balendres, M.A.O.; De la Cueva, F.M. Mutations associated with fungicide resistance in Colletotrichum species. Phytoparasitica 2023, 5, 569–592. [Google Scholar] [CrossRef]
- Leandero-Valenzuela, N.; Lara-Viveros, F.M.; Andrade-Hoyos, P.; Aguilar-Pérez, L.A.; Aguado-Rodríguez, G.J. Alternativas para el control de Colletotrichum spp. Rev. Mexicana Cienc. Agric. 2016, 7, 1189–1198. [Google Scholar] [CrossRef]
- Chávez-Ramírez, B.; Kerber-Díaz, J.C.; Acoltzi-Conde, M.C.; Ibarra, J.A.; Vásquez-Murrieta, M.S.; Estrada-de los Santos, P. Inhibition of Rhizoctonia solani RhCh-14 and Pythium ultimum PyFr-14 by Paenibacillus polymyxa NMA1017 and Burkholderia cenocepacia CACua-24: A proposal for biocontrol of phytopathogenic fungi. Microbiol. Res. 2020, 230, 126347. [Google Scholar] [CrossRef]
- Chávez-Ramírez, B.; Rodríguez-Velázquez, N.D.; Mondragón-Talonia, C.M.; Avendaño-Arrazate, C.H.; Martínez-Bolaños, M.; Vásquez-Murrieta, M.S.; Estrada de los Santos, P. Paenibacillus polymyxa NMA1017 as a potential biocontrol agent of Phytophthora tropicalis, causal agent of cacao black pod rot in Chiapas, Mexico. Antonie Leeuwenhoek 2021, 114, 55–68. [Google Scholar] [CrossRef]
- Gómez-de la Cruz, I.; Chávez-Ramírez, B.; Avendaño-Arrazate, C.H.; Morales-García, Y.E.; Muñoz-Rojas, J.; Estrada-de los Santos, P. Optimization of Paenibacillus sp. NMA1017 application as a biocontrol agent for Phytophthora tropicalis and Moniliophthora roreri in cacao-growing fields in Chiapas, Mexico. Plants 2023, 12, 2336. [Google Scholar] [CrossRef]
- Gómez-de la Cruz, I.; Martínez-Bolaños, M.; Chávez-Ramírez, B.; Estrada-de los Santos, P. Biocontrol of Hemileia vastatrix, the causal agent of coffee leaf rust, by Paenibacillus sp. NMA1017. Plant Dis. 2024, 108, 3163–3169. [Google Scholar] [CrossRef] [PubMed]
- Martínez-Morales, A.; Hernández-Hernández, L.U.; Osorio-Osorio, R.; Alia-Tejacal, I.; López-Martínez, V.; Bautista-Baños, S.; Sánchez, D.G. Incidencia y severidad de Botryodiplodia theobromae en frutos de zapote mamey en Jalpa de Méndez, Tabasco, México. UDO Ag. 2008, 8, 29–32. [Google Scholar]
- Castro-Pérez, L.M.; Saquero, M.J.; Beltrán-Herrera, J.D. Caracterización morfológica y patogénica de Colletotrichum spp. como agente causal de la antracnosis en Dioscorea sp. Rev. Colomb. Biotecnol. 2003, 5, 24–35. [Google Scholar]
- Allers, T.; Lichten, M. A method for preparing genomic DNA that restrains branch migration of holliday junctions. Nucleic Acids Res. 2000, 28, e6. [Google Scholar] [CrossRef]
- White, T.J.; Bruns, T.; Lee, S.; Taylor, J. Amplification and direct sequencing of fungal ribosomal RNA genes for phylogenetics. In PCR Protocols: A Guide to Methods and Applications; Innis, M.A., Sninsky, J.J., Gelfand, D.H., White, T.J., Eds.; Academic Press, Inc.: Cambridge, MA, USA, 1989; pp. 315–322. [Google Scholar] [CrossRef]
- Guindon, S.; Dufayard, J.F.; Lefort, V.; Anisimova, M.; Hordijk, W.; Gascuel, O. New algorithms, and methods to estimate maximum-likelihood phylogenies: Assessing the performance of PhyML 3.0. Syst. Biol. 2010, 59, 307–321. [Google Scholar] [CrossRef]
- Tamura, K.; Stecher, G.; Kumar, S. MEGA11: Molecular Evolutionary Genetics Analysis Version 11. Mol. Biol. Evol. 2021, 38, 3022–3027. [Google Scholar] [CrossRef]
- Oliveira, R.; Bouhmidi, K.; Trapero, A.; Moral, J. Caracterización morfológica y cultural de aislados de Colletotrichum spp. causantes de la antracnosis del olivo. Bol. Sanid. Veg. Plagas 2005, 31, 531–548. [Google Scholar]
- Weir, B.S.; Johnston, P.R.; Damm, U. The Colletotrichum gloeosporioides species complex. Stud. Mycol. 2012, 73, 115–180. [Google Scholar] [CrossRef] [PubMed]
- Montero-Tavera, V.; Morales-García, J.L.; González-Chavira, M.M.; Anaya-López, J.L.; Corona-Torres, T. Diversidad genética, patogénica y morfológica del hongo Colletotrichum gloeosporioides (Penz.) de Michoacán, México. Rev. Mexicana Cienc. Agric. 2010, 1, 159–174. [Google Scholar]
- Crisci, J.V.; Stuessy, T.F. Determining primitive character states for phylogenetic reconstruction. Syst. Bot. 1980, 5, 112. [Google Scholar] [CrossRef]
- Ezziyyani, M.; Sánchez, C.P.; Requena, M.E.; Rubio, L.; Castillo, M.E.C. Biocontrol por Streptomyces rochei–Ziyani–, de la podredumbre del pimiento (Capsicum annuum L.) causada por Phytophthora capsici. Ann. Biol. 2004, 26, 69–78. [Google Scholar]
- Mohali-Castillo, S.R.; Stewart, J.E. First report of Colletotrichum siamense associated with anthracnose on Theobroma cacao fruits in Venezuela. New Dis. Rep. 2022, 46, e12131. [Google Scholar] [CrossRef]
- Hernández-Gómez, E.; Hernández-Morales, J.; Avendaño-Arrazate, H.; López-Guillen, G.; Garrido-Ramírez, R.; Romero-Nápoles, J.; Romero-Nápoles, J.; Nava-Díaz, C. Factores socieconómicos y parasitológicos que limitan la producción del cacao en Chiapas, México. Rev. Mex. Fitopatol. 2015, 33, 232–246. [Google Scholar]
- Gobierno del Estado de Chiapas. Programa Regional 513 de Desarrollo Región X Soconusco. Secretaría de Desarrollo y Obras Públicas. 2010. Available online: https://www.haciendachiapas.gob.mx/planeacion/Informacion/Desarrollo-Regional/prog-regionales/SOCONUSCO.pdf (accessed on 22 October 2024).
- Mohanan, R.C.; Kaveriappa, K.M.; Nambiar, K.K.N. Epidemiological studies of Colletotrichum gloeosporioides disease of cocoa. Ann. Appl. Biol. 1989, 114, 15–22. [Google Scholar] [CrossRef]
- Crouch, J.A.; Beirn, L.A.; Cortese, L.M.; Bonos, S.A.; Clarke, B.B. Anthracnose disease of switchgrass caused by the novel fungal species Colletotrichum navitas. Mycol. Res. 2009, 113, 1411–1421. [Google Scholar] [CrossRef]
- Hyde, K.D.; Cai, L.; Cannon, P.F.; Crouch, J.A.; Crous, P.W.; Damm, U.; Goodwin, P.H.; Chen, H.; Johnston, P.R.; Jones, E.B.G.; et al. Colletotrichum names in current use. Fungal Divers. 2009, 39, 147–182. [Google Scholar]
- Torres-Calzada, C.; Tapia-Tussell, R.; Higuera-Ciapara, I.; Huchin-Poot, E.; Martin-Mex, R.; Nexticapan-Garcez, A.; Perez-Brito, D. Characterization of Colletotrichum truncatum from papaya, pepper and physic nut based on phylogeny, morphology and pathogenicity. Plant Pathol. 2018, 67, 821–830. [Google Scholar] [CrossRef]
- Penet, L.; Guyader, S.; Petro, D.; Salles, M.; Bussière, F. Direct splash dispersal prevails over indirect and subsequent spread during rains in Colletotrichum gloeosporioides infecting yams. PLoS ONE 2014, 9, e115757. [Google Scholar] [CrossRef] [PubMed]
- Damm, U.; Cannon, P.F.; Woudenberg, J.H.C.; Crous, P.W. The Colletotrichum acutatum species complex. Stud. Mycol. 2012, 73, 37–113. [Google Scholar] [CrossRef]
- Mohamed, A.I.; Sundram, S.; Ramachandran, V.; Abu, S.I. An in vitro investigation of Malaysian Phytophthora palmivora isolates and pathogenicity study on oil palm. J. Phytopathol. 2017, 165, 800–812. [Google Scholar] [CrossRef]
- Manova, V.; Stoyanova, Z.; Rodeva, R.; Boycheva, I.; Korpelaien, H.; Vesterien, E.; Wirta, H.; Bonchev, G. Morphological, pathological and genetic diversity of the Colletotrichum species, pathogenic on solanaceus vegetable crops in Burlgaria. J. Fungi 2022, 8, 1123. [Google Scholar] [CrossRef]
- Yee, M.F.; Sariah, M. Comparative morphology and characterization of Colletotrichum isolates occurring on cocoa in Malaysia. Pertanika J. Trop. Agric. Sci. 1983, 16, 45–51. [Google Scholar]
- Cannon, P.F.; Damm, U.; Johnston, P.R.; Weir, B.S. Colletotrichum current status and future directions. Stud. Mycol. 2012, 73, 181–213. [Google Scholar] [CrossRef]
- Lelwala, R.V.; Korhonen, P.K.; Young, N.D.; Scott, J.B.; Ades, P.K.; Gasser, R.B.; Taylor, P.W. Comparative genome analysis indicates high evolutionary potential of pathogenicity genes in Colletotrichum tanaceti. PLoS ONE 2019, 14, e0212248. [Google Scholar] [CrossRef]
- Kim, Y.S.; Balaraju, K.; Jeon, Y. Biological control of apple anthracnose by Paenibacillus polymyxa APEC128, an antagonistic Rhizobacterium. Plant Pathol. J. 2016, 32, 251–259. [Google Scholar] [CrossRef]
- Kim, Y.S.; Balaraju, K.; Jeon, Y. Effects of rhizobacteria Paenibacillus polymyxa APEC136 and Bacillus subtilis APEC170 on biocontrol of postharvest pathogens of apple fruits. J. Zhejiang Univ. Sci. B 2016, 17, 931–940. [Google Scholar] [CrossRef]
- Suryanto, D.; Wahyuni, S.; Siregar, E.B.M.; Munir, E. Utilization of chitinolytic bacterial isolates to control anthracnose of cocoa leaf caused by Colletotrichum gloeosporioides. Afr. J. Biotechnol. 2014, 13, 1631–1637. [Google Scholar] [CrossRef]
- Carrillo-Fasio, J.A.; García-Estrada, R.S.; Muy-Rangel, M.D.; Sañudo-Barajas, A.; Márquez-Zequera, I.; Allende-Molar, R.; de la Garza Ruiz, Z.; Vera, M.P.; Fentanes, E.G. Control biológico de antracnosis Colletotrichum gloeosporioides (Penz.) Penz. y Sacc. y su efecto en la calidad postcosecha del mango (Mangifera indica L.) en Sinaloa, México. Rev. Mex. Fitopatol. 2005, 23, 24–32. [Google Scholar]
- Galindo, E.; Serrano-Carreón, L.; Gutiérrez, C.; Allende, R.; Balderas, K.; Patiño, M.; Trejo, M.; Wong, M.A.; Rayo, E.; Isauro, D.; et al. The challenges of introducing a new biofungicide to the market: A case study. Electron. J. Biotechnol. 2013, 16, 5. [Google Scholar] [CrossRef]
- Shi, X.; Wang, S.; Duan, X.; Wang, Y.; Liu, F.; Laborda, P. Biocontrol strategies for the management of Colletotrichum species in postharvest fruits. Crop Prot. 2021, 141, 105454. [Google Scholar] [CrossRef]
- Lee, B.; Chen, P.; Chen, C. Suppression of strawberry anthracnose by Paenibacillus polymyxa TP3 in situ and from a distance. Plant Dis. 2024, 108, 700–710. [Google Scholar] [CrossRef]
- Sinuco-León, D.C.; Coconubo-Guio, L.C.; Castellanos-Hernández, L. Fungicidal activity of volatile organic compounds from Paenibacillus bacteria against Colletotrichum gloeosporioides. Rev. Colomb. Quim. 2020, 49, 20–25. [Google Scholar] [CrossRef]

| Site | County | Coordinates | Isolates | Incidence % |
|---|---|---|---|---|
| 1 | Suchiate | 14°40′47.8 N 92°10′15.6 W | 29 | 1.66 |
| 2 | Frontera Hidalgo | 14°45′07.8 N 92°11′27.6 W | 3 | 11.63 |
| 3 | Metapa | 14°48′56.5 N 92°12′01.4 W | 3 | 1.06 |
| 4 | Cacahoatán | 14°59.540′ N 092°11.166′ W | 12 | 2.97 |
| 5 | Tuxtla Chico | 14°54.112′ N 092°11.942′ W | 5 | 3.22 |
| 6 | Huehuetán (Tepehuitz) | 15°03.882′ N 092°20.078′ W | 3 | 2.76 |
| 7 | Huehuetán (Cantón Santa Elena) | 15°00.797′ N 092°26.476′ W | 5 | 1.49 |
| 8 | Mazatán | 14°49.651′ N 092°28.429′ W | 12 | 4.28 |
| 9 | Tuzantán (Cantón el Vado) | 15°05.193 N 092°22.232′ W | 2 | 3.55 |
| 10 | Tuzantán (Cantón el Capulín) | 15°06.625′ N 092°26.231′ W | 1 | 1.77 |
| 11 | Huixtla (Piedra Canoa) | 15°10.608′ N 92°26.410′ W | 9 | 2.24 |
| 12 | Huixtla (La Unión) | 15°03.686′ N 092°30.376′ W | 3 | 1.49 |
| 13 | Tapachula | 14°52.565′ N 092°21.413′ W | 4 | 0.6 |
| 14 | Villa Comaltitilán (Monteflor) | 14°52.555′ N 092°21.426′ W | 18 | 3.02 |
| 15 | Villa Comaltitlán (Los Cocos) | 15°19.526′ N 092°34.261′ W | 9 | 5.69 |
| 16 | Acacoyagua (Ejido los Cocos) | 15°23.628′ N 092°39.466′ W | 14 | 3.41 |
| 17 | Acacoyagua (27 de Mayo Amp. Madronal) | 15°23.625′ N 092°39.467′ W | 10 | 2.2 |
Disclaimer/Publisher’s Note: The statements, opinions and data contained in all publications are solely those of the individual author(s) and contributor(s) and not of MDPI and/or the editor(s). MDPI and/or the editor(s) disclaim responsibility for any injury to people or property resulting from any ideas, methods, instructions or products referred to in the content. |
© 2025 by the authors. Licensee MDPI, Basel, Switzerland. This article is an open access article distributed under the terms and conditions of the Creative Commons Attribution (CC BY) license (https://creativecommons.org/licenses/by/4.0/).
Share and Cite
Rodríguez-Velázquez, N.D.; Gómez-de la Cruz, I.; López-Guillen, G.; Chávez-Ramírez, B.; Estrada-de los Santos, P. Isolation and Biological Control of Colletotrichum sp. Causing Anthracnosis in Theobroma cacao L. in Chiapas, Mexico. J. Fungi 2025, 11, 312. https://doi.org/10.3390/jof11040312
Rodríguez-Velázquez ND, Gómez-de la Cruz I, López-Guillen G, Chávez-Ramírez B, Estrada-de los Santos P. Isolation and Biological Control of Colletotrichum sp. Causing Anthracnosis in Theobroma cacao L. in Chiapas, Mexico. Journal of Fungi. 2025; 11(4):312. https://doi.org/10.3390/jof11040312
Chicago/Turabian StyleRodríguez-Velázquez, Nadia Denisse, Irene Gómez-de la Cruz, Guillermo López-Guillen, Belén Chávez-Ramírez, and Paulina Estrada-de los Santos. 2025. "Isolation and Biological Control of Colletotrichum sp. Causing Anthracnosis in Theobroma cacao L. in Chiapas, Mexico" Journal of Fungi 11, no. 4: 312. https://doi.org/10.3390/jof11040312
APA StyleRodríguez-Velázquez, N. D., Gómez-de la Cruz, I., López-Guillen, G., Chávez-Ramírez, B., & Estrada-de los Santos, P. (2025). Isolation and Biological Control of Colletotrichum sp. Causing Anthracnosis in Theobroma cacao L. in Chiapas, Mexico. Journal of Fungi, 11(4), 312. https://doi.org/10.3390/jof11040312

